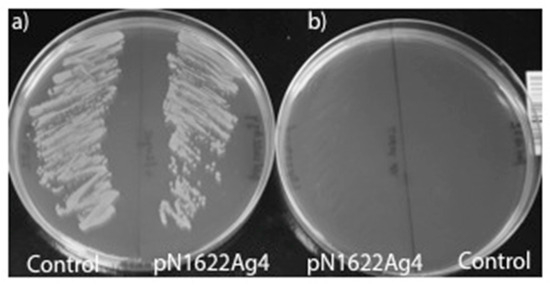

Abstract
Bacillus thuringiensis (Bt) produces, during its vegetative growth, some insecticidal proteins that are secreted and diluted into the culture medium. These proteins are commonly known as vegetative insecticidal proteins (Vips), and include binary Vpb/Vpa proteins (formerly known as Vip1/Vip2) with coleopteran activity; Vip (formerly Vip3) with activity against lepidopterans; and Vpb4 proteins (formerly Vip4), also with coleopteran activity. Vip proteins are highly toxic to different species of lepidopteran pests; however, the difficulty in producing them in a concentrated form has not allowed their development as formulated biopesticides, and they are relegated to only being produced in transgenic crops. In this work, we demonstrated that the gene encoding the Vip protein Vip3Ag4 could be successfully expressed in an asporogenic strain of Bacillus megaterium using (D)-xylose as a low-cost inductor. Under certain conditions (37 °C and induction with 0.5% w/v xylose), active Vip3Ag4 protein was primarily produced in soluble form, remaining encapsulated within the cell wall of B. megaterium. After treatment with lugol (1% for 4 h), induced cells were completely killed (fixed) but maintained the functional Vip3Ag4 protein, which resulted in above 95% mortality against first-instar larvae of Chrysodeixis chalcites, Helicoverpa armigera, Spodoptera exigua, S. frugiperda, S. littoralis and Trichoplusia ni. The fact that the recombinant Vip3Ag4 protein was successfully produced in a soluble and an active form in this bacterium (with a low-cost inductor) suggests that B. megaterium is one of the hosts of choice for the production of sprayable formulations in “killed-microbial pesticides”, based on Vip3 proteins from Bt.
1. Introduction
Bacillus thuringiensis (Bt) is a Gram-positive spore-forming bacterium that produces several insecticidal proteins of different types. The three-domain crystal (Cry) proteins, commonly known as δ-endotoxins, are not only the most abundant but also the most studied insecticidal proteins from this bacterium [1]. These proteins are synthesized during sporulation and aggregate to form parasporal crystals, exhibiting pesticidal activity against species of different orders, including Lepidoptera, Diptera and Coleoptera, but also against some phytopathogenic nematodes [2]. Wild-type strains of Bt serovar israelensis also produce other proteins commonly known as Cyt (cytolytic) proteins, which are synthesized and crystallized together with Cry proteins, exhibiting toxic activity against mosquitoes and black flies [3]. The mixed spores and parasporal crystals have been successfully used as the active material of a number of Bt-based formulates with insecticidal activity [4,5]. In addition, there are several cry genes that have been used, alone or in combination, for the construction of transgenic plants expressing Bt proteins with resistance against some insect pests, which are commonly known as Bt plants (e.g., Bt corn and Bt cotton) [6,7,8]. Other Bt proteins with insecticidal activity, discovered later than Cry proteins, are produced during the vegetative growth phase and posteriorly secreted into the culture medium, and these are commonly known as vegetative insecticidal proteins [9]. These secretable proteins include binary Vpb1/Vpa2 (formerly Vip1/Vip2) proteins with toxic activity against coleopteran pests [7]; Vip proteins (formerly Vip3) with insecticidal activity against lepidopteran insects [6]; and the most recently discovered, Vpb4 (formerly Vip4), with activity against Diabrotica virgifera virgifera (Coleoptera) [9]. Some of the genes encoding Vip3A proteins have also been used in the construction of transgenic plants. For example, cotton Cot102XCot67b co-expresses both Cry1Ab and Vip3Aa19 toxins to protect cotton from Helicoverpa zea and Heliothis virescens [10]. Therefore, the Vip3 proteins have not been used as the active ingredient of insecticide formulations because they contain a signal peptide sequence driving their secretion into the culture medium [6]. This feature has prevented the production of these secretable insecticidal proteins in a concentrated form, necessary, for example, for the production of a Vip-based formulation. However, a recent report showed that Vip3 protein also remains attached in the spores of Bt HD-1 strain [11].
Therefore, the aim of this work was to set up a microbial system suitable for the production of encapsulated and functional (insecticidal) Vip3 proteins using a safe bacterium that poses no risk to humans or to terrestrial or aquatic wildlife if released into the environment. In the scientific literature, there are several examples of systems using heterologous bacteria for the production of different types of proteins, including insecticidal Cry proteins from Bt. The best known is probably the use of non-pathogenic strains of the Gram-negative bacterium Pseudomonas fluorescens for microencapsulating Bt crystal proteins [12], or even more, secretable Cry1I and Vip3 proteins [13]. This strategy was initially used by the company Mycogen Corporation for two commercial products, namely, MVP™ (Mycogen Corporation) for the control of Lepidoptera and M-TRAK™ to control beetles [14]. After the induction of protein expression, P. fluorescens cells containing the Cry protein are killed through the application of physical or chemical methods (e.g., chemical fixation with formaldehyde or lugol). This process significantly improves the effectiveness of the insecticidal proteins by increasing their persistence in the environment and protecting them against inactivation induced by ultraviolet light from the sun [15]. However, the natural presence of endotoxins (lipid A) in the membrane of the Gram-negative bacteria is, in fact, a very inconvenient feature. Using a different approach, Lampel et al. [16] introduced a cry gene in Clavibacter xyli var. cynodontis, an endophytic Gram-positive bacterium that naturally colonizes the vascular system of various plants, including maize. The cry gene introduced into this bacterium encodes the Cry1Ac protein, which is very toxic to Ostrinia nubulalis larvae [16]. Nonetheless, to our knowledge, there are not yet any Gram-positive bacterial systems developed for the heterologous production and encapsulation of Vip3 proteins suitable for the production of biopesticide formulations.
In this work, we demonstrated that B. megaterium could be successfully used to produce and encapsulate Vip3 proteins. B. megaterium is an aerobic, spore-forming and non-pathogenic bacterium, is able to grow on a wide variety of substrates, does not contain any endotoxins and is often found colonizing the leaves of cotton plants [17]. Moreover, B. megaterium has been described as a GRAS (Generally Recognized as Safe) organism by the US Food and Drug Administration [18]. Currently, there are various expression vectors available that are useful for transforming B. megaterium [19] and allow for the intracellular expression of proteins using (D)-xylose as a low-cost inductor of gene expression. In addition, the B. megaterium expression system has been also used in the industrial production of a wide range of proteins with different purposes [20,21]. We used the shuttle vector pN-His-TEV1622 (Mobitec) for protein expression in B. megaterium and for the production of active microencapsulated Vip3 proteins, as a means of obtaining an active concentrated ingredient for the further development of novel Bt-based biopesticide formulations.
2. Materials and Methods
2.1. Bacterial Strains and Growth Conditions
The Bt ZaB5.3 and B. megaterium WH320 (Mobitec) strains used in this work were cultured in Luria–Bertani (LB) medium (1% tryptone, 0.5% yeast extract and 1% NaCl, pH 7.0) at 28 °C and 37 °C, respectively, with orbital shaking at 200 RPM. The Escherichia coli strain DH5α was used for routine DNA manipulations and also cultured in LB medium at 37 °C with orbital shaking at 200 RPM.
2.2. Amplification and Cloning of vip3Ag4 Gene
Total DNA was obtained from the Bt strain ZaB5.3 as previously described by Ruiz de Escudero et al. (2006) [22]. The vip3Ag4 gene (Acc. Num. HQ414237) [23] was obtained via polymerase chain reaction (PCR) using specific primers that hybridize and modify the sequence via site-directed mutagenesis, allowing for the addition of restriction sites XmaI (5′-CCCGGGATGAACAAGAATAATACTAA-3′) and KpnI (5′-GGTACCTCACTTAATCGAAAAATTCC-3′) immediately before and after the start (ATG) and stop (TGA) codons, respectively. Each PCR reaction was performed in a 25 μL mixture (final volume) using proof reading PrimeSTAR HS DNA polymerase (Takara) and 5 μL total DNA (100 ng) in an Eppendorf Mastercycler thermal cycler (Eppendorf) using the following cycling conditions: 4 min initial denaturation at 94 °C, 35 amplification cycles (1 min denaturation at 94 °C, 1 min annealing at 50 °C and 2.5 min extension at 72 °C) with a final extension step at 72 °C for 10 min. The obtained PCR amplicon was electrophoresed in 1% agarose gel, purified from agarose using a NucleoSpin Extract II kit (Macherey-Nagel), cloned in pGEM-T easy (Promega), sequenced, and the construct designated as pGEM-Ag4. This modification facilitated the digestion with enzymes XmaI and KpnI and the subcloning of the modified vip3Ag4 amplicon into pre-digested E. coli/B. megaterium shuttle expression vector pN-His-TEV1622 [21], obtaining the pN1622-Ag4 construct. In this construction, the vip3Ag4 gene was introduced in-frame and under the control of the xylose-inducible promoter (PxylA) and N-terminally fused to the poly-histidine tag encoded in the pN-His-TEV1622 vector. This construction and the empty vector (control without inserted gene) were transformed into protoplasts of B. megaterium WH320 following the manufacturer’s instructions (Mobitec). The transformed cells of B. megaterium acquired tetracycline resistance and were selected in solid LB medium supplemented with tetracycline at a final concentration of 10 μg/mL (LB Tc10). A clone of the recombinant B. megaterium strain was selected and sequenced using sequencing forward (5′-TCCTTTGTTTATCCACCGAA-3′) and reverse (5′-TCGGGTTTCGCCACCTCTGA-3′) primers in order to verify the correct in-frame N-terminal fusion to the polyhistidine tag encoded in the pN-His-TEV1622 shuttle expression vector.
2.3. Amplification and Cloning of vip3Ag4 Gene
The B. megaterium strain transformed using the pN1622Ag4 construct was grown in 2×TY medium (37 °C and 200 RPM) with tetracycline at a final concentration of 10 μg/mL. After reaching an optical density of 0.3 at 600 nm, protein expression was induced by adding (D)-xylose (Merck) at a final concentration of 0.5% (w/v). The induction of protein expression was continued overnight and from one liter of 2×TY medium, 500 mL was used for the extraction and purification of the recombinant protein and the remaining 500 mL for bioassays with the Vip3Ag4 protein encapsulated in the killed bacterium. Samples were centrifuged at 5000× g for 15 min at 4 °C and the obtained pellet weighed and resuspended with 3 mL sonication buffer (50 mM NaH2PO4, pH 8.0, 300 mM NaCl, 3 mg/mL lysozyme, 25 U Benzonase (Novagen) and 100 μM phenylmethylsulfonyl fluoride (PMSF) per gram of pellet). Samples were further incubated at 37 °C for 60 min and sonicated in ice water using a Branson analog Sonifier 250 (Branson Ultrasonics Corporation) by applying two 1 min pulses with a constant duty cycle at 60 W, separated by a 1 min cooling period. Insoluble material was pelleted via centrifugation at 12,000× g for 30 min at 4 °C and the soluble cellular fraction filtered through sterile 0.45 and 0.22 μm syringe filters. Then, protein purification was performed using Protino Ni-TED 2000 Packed Columns according to the manufacturer’s instructions (Macherey-Nagel). Additionally, 500 mL of induced 2×TY supernatant was also passed through fresh Protino Ni-TED 2000 Packed Columns (Macherey-Nagel) in an attempt to detect whether the recombinant Vip3Ag4 protein was partially secreted to the culture medium. The resultant expressed (soluble) Vip3Ag4 protein was then analyzed via sodium dodecyl sulfate–polyacrylamide gel electrophoresis (SDS–PAGE), and stained with Coomassie brilliant blue R-250 (Sigma-Aldrich). The protein concentration was estimated using the Bradford method [24] after imaging (scanning) via SDS-PAGE gel densitometry using GelEval package (FrogDance software).
2.4. Cell Fixation and Counting
The induced cells were harvested via centrifugation at 6000 RPM at 4 °C and fixed as previously described [25]. The cell pellet was incubated at room temperature in 1% lugol for 4 h with gentle orbital shaking, washed three times with sterile distilled water and resuspended in 20 mL of sterile distilled water. The same 1% lugol treatment was also conducted on a control cell pellet containing the empty pN-His-TEV1622 shuttle expression vector. The estimation of the number of viable cells, in terms of colony-forming units per milliliter (CFU/mL) of culture medium, was performed immediately after the induction step was completed via surface plating of the serial dilutions in 9 cm-diameter Petri dishes containing LB Tc10 medium. A cell viability assay was also performed, via the streak plate technique, with a loopful of 1% lugol-treated and non-treated cells separately loaded onto plates containing LB Tc10 medium.
2.5. Preliminary Insect Bioassays Using Microencapsulated Vip3Ag4 Protein
B. megaterium strains harboring pN1622Ag4 and the empty pN-His-TEV1622 vector as the control were grown over night until they reached stationary phase. Bioassays were conducted by adding 100 μL of 1% lugol-fixed bacterial suspensions on the surface of a solidified artificial diet for lepidopterans [26]. The suspensions were immediately distributed onto the surface of 9 cm-diameter Petri dishes using a sterile Drigalsky spatula and allowed to completely dry for 30 min in a laminar flow hood. Then, 25 neonate larvae of the lepidopteran pest species Chrysodeixis chalcites, Helicoverpa armigera, Spodoptera exigua, S. frugiperda, S. littoralis and Trichoplusia ni were added to each plate and incubated at 25 °C, at 60 ± 5% RH, and over a 16:8 (light/dark [h]) photoperiod. Mortality was registered at 3 and 5 days after treatment.
3. Results
3.1. Vip3Ag4 Insecticidal Gene Cloning in B. Megaterium
The analysis of the pN1622Ag4 construct was performed via restriction endonuclease digestion with XmaI and KpnI enzymes, which produced two DNA fragments of the expected size and corresponding to pN-His-TEV1622 (6589 bp) and the vip3Ag4 insecticidal gene insert (2364 bp). Furthermore, the analysis performed via PCR showed amplification of the vip3Ag4 gene amplicon of approximately 2.4 kb (Figure 1). Full-length sequencing analysis of the insert demonstrated that no mismatches were present in the vip3Ag4 coding sequence of the pN1622Ag4 construct.

Figure 1.
(a) Analysis of REN pN1622Ag4 construction, (b) PCR analysis of the construction pN1622Ag4. (M) Molecular weight marker Hyperladder I (Labolan); (-) negative control; and (+) positive control.
3.2. Gene Expression in B. megaterium
SDS–PAGE analysis showed that the Vip3Ag4 protein was successfully expressed in B. megaterium and produced a major protein of the expected size (approx. 90 kDa) that was found in both the soluble and insoluble fractions (pellet), indicating that recombinant B. megaterium produced both insoluble and soluble fractions (Figure 2). The protein yield estimated reached 3.1 mg per 5 g of cell pellet (~1 mg μg/mL of elution buffer) from 500 mL of 2×TY medium. In addition, attempts to purify the recombinant protein from the culture medium failed, showing no detectable amounts of recombinant Vip3Ag4 protein in the SDS-PAGE gel electrophoresis analysis.

Figure 2.
Polyacrylamide gel electrophoresis analysis of the recombinant Vip3Ag4 protein expressed in B. megaterium. M: molecular weight marker (BioRad), A: cellular pellet, B: cellular supernatant with soluble Vip3Ag4 protein (after sonication). F1, F2 and F3: purified soluble fractions of 6× His-tagged Vip3Ag4 protein (Protino Ni-TED 1000).
3.3. Fixation, Counting and Viability Analysis
The number of viable B. megaterium cells after induction was 1 × 108 CFU/mL. Approximately 5 g (wet weight) of pellet per 500 mL of culture medium was obtained. Once the cells were fixed with 1% lugol, they were unable to grow on LB Tc10 medium (Figure 3).
Figure 3.
Viability analysis in Petri plates with Lb Tc10 cells of B. megaterium pN1622Ag4 control. (a) Untreated cells and (b) cells fixed (killed) with Lugol 1%.
3.4. Preliminary Bioassays
Plate (preliminary) bioassays showed that the induced cells (lugol-fixed) maintained functional Vip3Ag4 protein, which resulted in above 95% mortality against first-instar larvae of C. chalcites, H. armigera, S. exigua, S. frugiperda, S. littoralis and T. ni (Figure 4).

Figure 4.
Plate assay performed with B. megaterium control (empty plasmid) and cell-encapsulated Vip3Ag4 protein after 5 days.
4. Discussion
Bacillus thuringiensis synthesizes an extraordinary diversity of insecticidal proteins and has demonstrated its potential and safety as a biocontrol agent for more than four decades [2,27]. These insecticidal proteins include both crystal and secretable proteins that are highly toxic against a wide range of invertebrate species [28,29,30,31]. Several natural B. thuringiensis strains have been incorporated successfully in the production of sprayable biopesticides wherein the active ingredient is a mixture of spores and crystal proteins. Genes encoding insecticidal proteins have also been used in novel insecticidal formulations and in the construction of transgenic crops [31]. However, vegetative or secreted insecticidal proteins (Vpb1/Vpa2, Vip3, Vpb4 and Sip1) are synthesized during the vegetative growth phase and subsequently secreted and diluted into the culture medium [6,7,9,32]. This feature has prevented the production of Bt-based biopesticide sprays where the active ingredient consists of a secretable insecticidal protein, limiting their production exclusively to transgenic crops, and suggesting that novel methods must be used in order to develop Vip3-based formulations suitable for the biocontrol of insect pests [33]. One option, successfully assessed in this work, is the expression and encapsulation of active vegetative insecticidal protein Vip3Ag4 in the asporogenic mutant strain WH320 of B. megaterium (Mobitec). This bacterium is able to produce high levels of intracellular recombinant proteins, does not produce significant amounts of alkaline proteases [19], is suitable for the production of proteins from small to industrial scale [21] and is non-pathogenic [34]. Moreover, this expression system has a wide range of plasmids suitable for the production of not only intracellular but also extracellular recombinant proteins that could be induced with low-price substrates such as xylose. In this work, we demonstrated for the first time that the gene encoding a Vip3 protein could be successfully expressed in this asporogenic strain of B. megaterium using xylose as a low-cost inductor of protein expression and retaining toxic activity against susceptible lepidopteran larvae after fixing the cells with lugol. Additional studies need to be performed in order to describe the protection potential of this method over abiotic factors including UV light, storage conditions (e.g., time of storage, optimum temperatures, salinity and pH). However, the fact that the recombinant Vip3Ag4 protein was successfully produced in a soluble and an active form in this bacterium, with a low-cost inductor, suggests that B. megaterium is one of the heterologous hosts of choice for the commercial production of Vip3 proteins from B. thuringiensis in “killed microbial pesticides”.
Author Contributions
Conceptualization, L.P. and P.C.; methodology, L.P. and I.R.d.E.; validation, L.P., I.R.d.E. and P.C.; formal analysis, L.P., F.M.-O. and I.R.d.E.; investigation, L.P., F.M.-O. and I.R.d.E.; resources, P.C.; data curation, L.P., F.M.-O. and I.R.d.E.; writing—original draft preparation, L.P., C.B. and P.C.; writing—review and editing, L.P., I.R.d.E., C.B. and P.C.; visualization, L.P.; supervision, P.C.; project administration, P.C.; funding acquisition, P.C. All authors have read and agreed to the published version of the manuscript.
Funding
This research was funded by the Spanish Ministry of Science and Innovation grant number AGL2009-13340-C02 and by the Universidad Pública de Navarra (PhD contract awarded to L.P.).
Institutional Review Board Statement
Not applicable.
Informed Consent Statement
Not applicable.
Data Availability Statement
The coding sequence used in this study is available at GenBank (Acc. Num. HQ414237).
Acknowledgments
We acknowledge the technical support of N. Gorría and I. Ibañez for their help in insect rearing.
Conflicts of Interest
The authors declare no conflict of interests.
References
- Schnepf, E.; Crickmore, N.; Van Rie, J.; Lereclus, D.; Baum, J.; Feitelson, J.; Zeigler, D.R.; Dean, D.H. Bacillus thuringiensis and its pesticidal crystal proteins. Microbiol. Mol. Biol. Rev. 1998, 62, 775–806. [Google Scholar] [CrossRef]
- Bravo, A.; Likitvivatanavong, S.; Gill, S.S.; Soberon, M. Bacillus thuringiensis: A story of a successful bioinsecticide. Insect. Biochem. Mol. Biol. 2011, 41, 423–431. [Google Scholar] [CrossRef]
- Soberón, M.; López-Díaz, J.A.; Bravo, A. Cyt toxins produced by Bacillus thuringiensis: A protein fold conserved in several pathogenic microorganisms. Peptides 2013, 41, 87–93. [Google Scholar] [CrossRef]
- Roh, J.Y.; Choi, J.Y.; Li, M.S.; Jin, B.R.; Je, Y.H. Bacillus thuringiensis as a specific, safe, and effective tool for insect pest control. J. Microbiol. Biotechnol. 2007, 17, 547–559. [Google Scholar]
- Kumar, S.; Chandra, A.; Pandey, K.C. Bacillus thuringiensis (Bt) transgenic crop: An environment friendly insect-pest management strategy. J. Environ. Biol. 2008, 29, 641–653. [Google Scholar]
- Estruch, J.J.; Warren, G.W.; Mullins, M.A.; Nye, G.J.; Craig, J.A.; Koziel, M.G. Vip3A, a novel Bacillus thuringiensis vegetative insecticidal protein with a wide spectrum of activities against lepidopteran insects. Proc. Natl. Acad. Sci. USA 1996, 93, 5389–5394. [Google Scholar] [CrossRef]
- Warren, G.W.; Koziel, M.G.; Mullins, M.A.; Nye, G.J.; Carr, B.; Desai, N.M.; Kostichka, K.; Duck, N.B.; Estruch, J.J. Auxiliary Proteins for Enhancing the Insecticidal Activity of Pesticidal Proteins. US Patent 5,770,696, 23 June 1998. [Google Scholar]
- Letourneau, D.K.; Hagen, J.A.; Robinson, G.S. Bt-Crops Evaluating Benefits under Cultivation and Risks from Escaped Transgenes in the Wild; CRC Press: Boca Raton, Fla, USA, 2002. [Google Scholar]
- Yin, Y.; Flasinski, S.; Moar, W.; Bowen, D.; Chay, C.; Milligan, J.; Kouadio, J.L.; Pan, A.; Werner, B.; Buckman, K.; et al. A new Bacillus thuringiensis protein for Western corn rootworm control. PLoS ONE 2020, 15, e0242791. [Google Scholar] [CrossRef]
- Kurtz, R.W.; McCaffery, A.; O’Reilly, D. Insect resistance management for Syngenta’s VipCot transgenic cotton. J. Invertebr. Pathol. 2007, 95, 227–230. [Google Scholar] [CrossRef]
- Hernández-Martínez, P.; Khorramnejad, A.; Escriche, A.B. The secret of HD1success: Why it can control effectively S. exigua larvae? In Proceedings of the 54th Annual Meeting of the Society for Invertebrate Pathology (Virtual Meeting), Nelson Mandela Bay, South Africa, 1–4 August 2022. [Google Scholar]
- Thompson, M.; Schwab, G.E. Delta-Endotoxin Expression in Pseudomonas fluorescens. US Patent 5,840,554, 18 June 1996. [Google Scholar]
- Hernández-Rodríguez, C.S.; Ruiz de Escudero, I.; Asensio, A.C.; Ferré, J.; Caballero, P. Encapsulation of the Bacillus thuringiensis secretable toxins Vip3Aa and Cry1Ia in Pseudomonas fluorescens. Biol. Control 2013, 66, 159–165. [Google Scholar] [CrossRef]
- Grace, J.K.; Ewart, D.M. Recombinant cells of Pseudomonas fluorescens: A highly palatable encapsulation for delivery of genetically engineered toxins to subterranean termites (Isoptera: Rhinotermitidae). Lett. Appl. Microbiol. 1996, 23, 183–186. [Google Scholar] [CrossRef]
- Gaertner, F.; Quick, C.; Thompson, M. CellCap: An Encapsulation System for Insecticidal Biotoxin Proteins; Marcel Dekker, Inc.: New York, NY, USA, 1993. [Google Scholar]
- Lampel, J.S.; Canter, G.L.; Dimock, M.B.; Kelly, J.L.; Anderson, J.J.; Uratani, B.B.; Foulke, J.S.; Turner, J.T. Integrative Cloning, Expression, and Stability of the cryIA(c) Gene from Bacillus thuringiensis subsp. kurstaki in a Recombinant Strain of Clavibacter xyli subsp. cynodontis. Appl. Environ. Microbiol. 1994, 60, 501–508. [Google Scholar]
- Bora, R.S.; Murty, M.G.; Shenbagarathai, R.; Sekar, V. Introduction of a lepidopteran-specific insecticidal crystal protein gene of Bacillus thuringiensis subsp. kurstaki by conjugal transfer into a Bacillus megaterium strain that persists in the cotton phyllosphere. Appl. Environ. Microbiol. 1994, 60, 214–222. [Google Scholar]
- Mohammed, Y.; Lee, B.; Kang, Z.; Du, G. Development of a two-step cultivation strategy for the production of vitamin B12 by Bacillus megaterium. Microb. Cell Fact. 2014, 13, 102. [Google Scholar] [CrossRef]
- Biedendieck, R.; Yang, Y.; Deckwer, W.D.; Malten, M.; Jahn, D. Plasmid system for the intracellular production and purification of affinity-tagged proteins in Bacillus megaterium. Biotechnol. Bioeng. 2007, 96, 525–537. [Google Scholar] [CrossRef]
- Korneli, C.; David, F.; Biedendieck, R.; Jahn, D.; Wittmann, C. Getting the big beast to work--systems biotechnology of Bacillus megaterium for novel high-value proteins. J. Biotechnol. 2013, 163, 87–96. [Google Scholar] [CrossRef]
- Vary, P.S.; Biedendieck, R.; Fuerch, T.; Meinhardt, F.; Rohde, M.; Deckwer, W.D.; Jahn, D. Bacillus megaterium—From simple soil bacterium to industrial protein production host. Appl. Microbiol. Biotechnol. 2007, 76, 957–967. [Google Scholar] [CrossRef]
- Ruiz de Escudero, I.; Estela, A.; Porcar, M.; Martínez, C.; Oguiza, J.A.; Escriche, B.; Ferré, J.; Caballero, P. Molecular and insecticidal characterization of a Cry1I protein toxic to insects of the families Noctuidae, Tortricidae, Plutellidae, and Chrysomelidae. Appl. Environ. Microbiol. 2006, 72, 4796–4804. [Google Scholar] [CrossRef]
- Palma, L.; Ruiz de Escudero, I.; Maeztu, M.; Caballero, P.; Muñoz, D. Screening of vip genes from a Spanish Bacillus thuringiensis collection and characterization of two novel Vip3 proteins highly-toxic to five lepidopteran crop pests. Biol. Control 2013, 66, 141–149. [Google Scholar] [CrossRef]
- Bradford, M.M. A rapid and sensitive method for the quantitation of microgram quantities of protein utilizing the principle of protein-dye binding. Anal. Biochem. 1976, 72, 248–254. [Google Scholar] [CrossRef]
- Barnes, A.; Cummings, S. Cellular Encapsulation of Biological Pesticides Produced by Expression of Heterologous Genes. US Patent 4,695,455, 22 September 1987. [Google Scholar]
- Greene, G.L.; Leppla, N.C.; Dickerson, W.A. Velvetbean Caterpillar: A Rearing Procedure and Artificial Medium123. J. Econ. Entomol. 1976, 69, 487–488. [Google Scholar] [CrossRef]
- Ibrahim, M.A.; Griko, N.; Junker, M.; Bulla, L.A. Bacillus thuringiensis: A genomics and proteomics perspective. Bioeng. Bugs 2010, 1, 31–50. [Google Scholar] [CrossRef] [PubMed]
- de Maagd, R. Bacillus thuringiensis-Based Products for Insect Pest Control. In Principles of Plant-Microbe Interactions; Lugtenberg, B., Ed.; Springer: Cham, Switzerland, 2015. [Google Scholar]
- van Frankenhuyzen, K. Cross-order and cross-phylum activity of Bacillus thuringiensis pesticidal proteins. J. Invertebr. Pathol. 2013, 114, 76–85. [Google Scholar] [CrossRef] [PubMed]
- van Frankenhuyzen, K. Insecticidal activity of Bacillus thuringiensis crystal proteins. J. Invertebr. Pathol. 2009, 101, 1–16. [Google Scholar] [CrossRef]
- Sanchis, V. From microbial sprays to insect-resistant transgenic plants: History of the biospesticide Bacillus thuringiensis. A review. Agron. Sustain. Dev. 2011, 31, 217–231. [Google Scholar] [CrossRef]
- Donovan, W.P.; Engleman, J.T.; Donovan, J.C.; Baum, J.A.; Bunkers, G.J.; Chi, D.J.; Clinton, W.P.; English, L.; Heck, G.R.; Ilagan, O.M.; et al. Discovery and characterization of Sip1A: A novel secreted protein from Bacillus thuringiensis with activity against coleopteran larvae. Appl. Microbiol. Biotechnol. 2006, 72, 713–719. [Google Scholar] [CrossRef]
- Qin, Y.; Ying, S.H.; Chen, Y.; Shen, Z.C.; Feng, M.G. Integration of insecticidal protein Vip3Aa1 into Beauveria bassiana enhances fungal virulence to Spodoptera litura larvae by cuticle and per Os infection. Appl. Environ. Microbiol. 2010, 76, 4611–4618. [Google Scholar] [CrossRef]
- Eppinger, M.; Bunk, B.; Johns, M.A.; Edirisinghe, J.N.; Kutumbaka, K.K.; Koenig, S.S.; Creasy, H.H.; Rosovitz, M.J.; Riley, D.R.; Daugherty, S.; et al. Genome sequences of the biotechnologically important Bacillus megaterium strains QM B1551 and DSM319. J. Bacteriol. 2011, 193, 4199–4213. [Google Scholar] [CrossRef]
Disclaimer/Publisher’s Note: The statements, opinions and data contained in all publications are solely those of the individual author(s) and contributor(s) and not of MDPI and/or the editor(s). MDPI and/or the editor(s) disclaim responsibility for any injury to people or property resulting from any ideas, methods, instructions or products referred to in the content. |
© 2023 by the authors. Licensee MDPI, Basel, Switzerland. This article is an open access article distributed under the terms and conditions of the Creative Commons Attribution (CC BY) license (https://creativecommons.org/licenses/by/4.0/).




